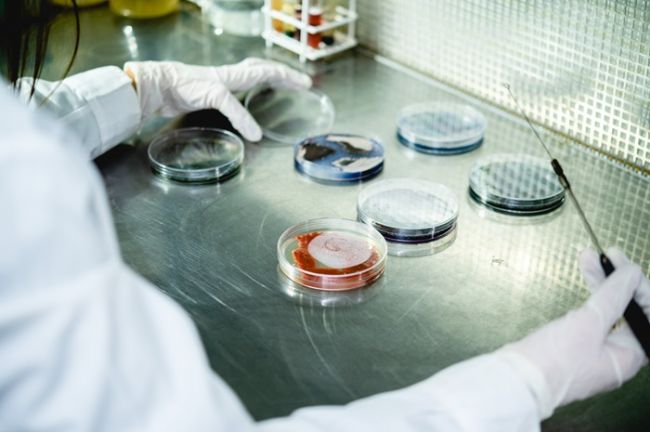

Tintte, una startup nacida en Córdoba, Argentina, busca transformar radicalmente la industria de la coloración textil. Su objetivo: reducir drásticamente el impacto ambiental de este sector a través del desarrollo de biopigmentos inteligentes producidos a partir de bacterias. Esta tecnología promete disminuir el uso de agua potable y energía, desintoxicando así un proceso que, según el Parlamento Europeo, es responsable del 20% de la contaminación del agua y del 3% de las emisiones globales de gases de efecto invernadero.
La idea inicial de Tintte surgió de un proyecto de biorremediación de lagos y diques contaminados. Al investigar las causas de la contaminación, los fundadores descubrieron que la industria de la coloración textil era una de las principales responsables. Decidieron entonces redirigir sus esfuerzos a entrenar bacterias para producir colorantes sostenibles y eficientes.
«Queremos cambiar radicalmente la manera en que hoy se tiñe, una meta ambiciosa pero necesaria«, afirma Gustavo Freytes, uno de los cofundadores junto a Rodrigo Asili y Magali Méndez.
Tecnología y propuesta de valor
El proceso desarrollado por Tintte permite teñir textiles utilizando hasta un 50% menos de agua y energía en comparación con los métodos tradicionales. Además, elimina el uso de auxiliares tóxicos, evitando así la contaminación de los efluentes. La startup destaca por dos factores clave:
- Innovación biotecnológica: Produce biopigmentos a través de la fermentación de microorganismos, un enfoque limpio y libre de químicos tóxicos.
- Compatibilidad y escalabilidad: Los biopigmentos pueden adaptarse a diversas fibras naturales y sintéticas sin necesidad de equipos especializados, lo que facilita su adopción por parte de la industria.
Crecimiento y proyección internacional
En menos de dos años, Tintte ha logrado importantes hitos:
- Firmó memorandos de entendimiento con TN & Platex, principal fabricante textil de Argentina, y con Vardhman, un referente en tintorería en India.
- Incrementó 100 veces la productividad en la producción de pigmentos.
- Avanzó en acuerdos de colaboración con marcas de moda internacionales en Asia, Europa, Estados Unidos y Latinoamérica.
Para 2025, la startup tiene como objetivo lanzar cápsulas comerciales y escalar su producción a nivel industrial, consolidando su posición en el mercado global de biopigmentos.

Ecosistema emprendedor y desafíos
Aunque valoran el talento humano y las redes de apoyo presentes en Argentina, los fundadores reconocen que factores como la burocracia y el acceso limitado a financiamiento dificultan el crecimiento de las startups en la región. «Existe el llamado ‘Latam Discount’, que recorta la valuación de las startups solo por estar localizadas en Latinoamérica», explica Freytes.
Un balance prometedor y un futuro ambicioso
El 2024 marcó un año clave para Tintte:
- Recibieron inversión de SF500, un fondo de capital de riesgo enfocado en biotecnología.
- Mudaron su laboratorio a la Fundación para el Progreso de la Medicina, uno de los más avanzados en Argentina.
- Firmaron acuerdos con marcas globales, consolidando su tecnología en el mercado.
Para 2025, Tintte planea llegar al mercado con cápsulas comerciales y continuar expandiéndose hacia mercados internacionales clave, liderando la transición hacia una industria textil más limpia y sostenible. Con un propósito claro y tecnología de punta, Tintte se posiciona como un referente en biotecnología aplicada al sector textil, llevando la innovación argentina al escenario global.








